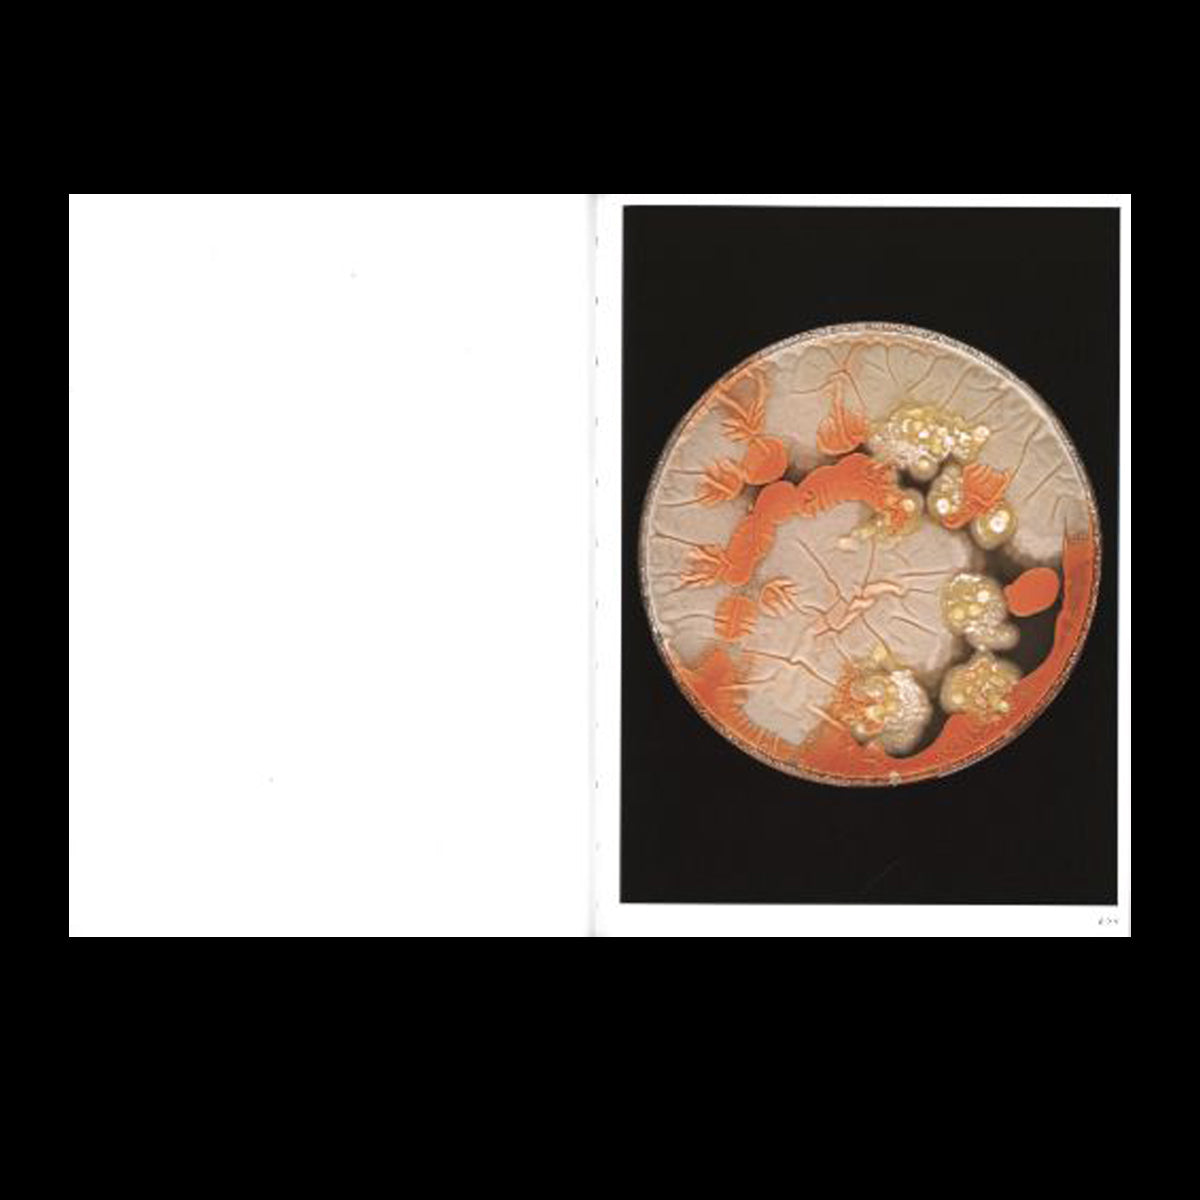
Unearthed

Unearthed
Unearthed
Unearthed - Ces microbes ont été préservés pendant des millénaires à des températures inférieures à zéro dans un écosystème unique que le changement climatique a maintenant mis en péril. Des scientifiques de l’Institut fédéral suisse de recherche sur la forêt, la neige et le paysage WSL ont prélevé des échantillons pour les étudier dans des conditions artificielles. L’artiste suisse a amené certains de ces microbes du laboratoire à son atelier, où elle les a cultivés et photographiés dans leurs boîtes de Pétri. Elle surveillait leur évolution rapide et aléatoire. De nulle part, la vie s’épanouissait soudainement, les formes et les couleurs changeaient constamment jusqu’à épuiser les ressources. Ces compositions abjectes et attrayantes sont devenues des sujets visuels incontrôlables. La publication présente des textes de scientifiques du WSL ainsi que des essais historiques, psychologiques et sociologiques. Les informations sur les micro-organismes et leurs capacités et occurrences spéciales donnent au lecteur l’occasion de connaître les protagonistes des images ; textes de Ivano Brunner, Lara Cristiano, Beat Frey, Marcia Phillips, Joel Rüthi, Jonas Schnydrig, Beat Stierli et Larissa Tiki Mbassi, photos en couleurs.
Share